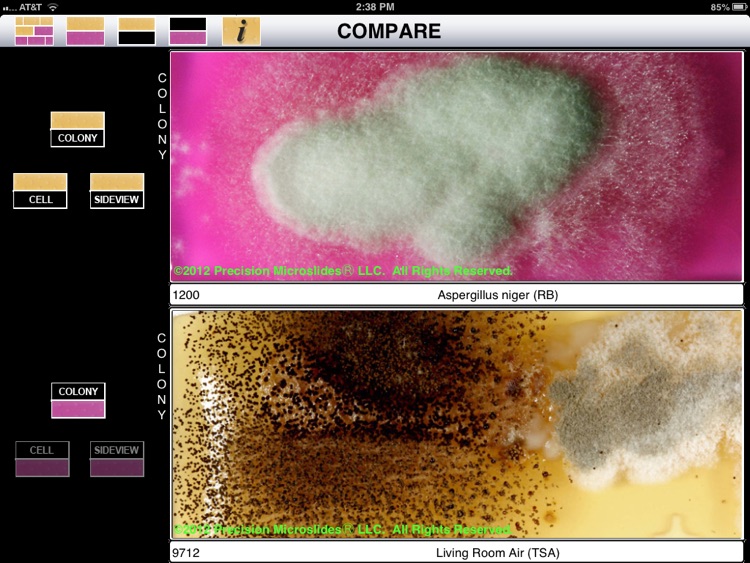
BioPaddles

BioPaddles® allows the user to presumptively identify microbe colonies on LaMotte BioPaddles® by comparing them to a library of over 250 standard images covering 30+ microbe genera in 5 microhabitats (AIR, WATER, SOIL, SURFACE, and FOOD) on 9 paddle agar types

BioPaddles



What is it about?
BioPaddles® allows the user to presumptively identify microbe colonies on LaMotte BioPaddles® by comparing them to a library of over 250 standard images covering 30+ microbe genera in 5 microhabitats (AIR, WATER, SOIL, SURFACE, and FOOD) on 9 paddle agar types. The image series includes side views, and top views at the colony and cell level.

App Screenshots

App Store Description
BioPaddles® allows the user to presumptively identify microbe colonies on LaMotte BioPaddles® by comparing them to a library of over 250 standard images covering 30+ microbe genera in 5 microhabitats (AIR, WATER, SOIL, SURFACE, and FOOD) on 9 paddle agar types. The image series includes side views, and top views at the colony and cell level.
This unique app allows digital image capture, import, and comparison. It also allows the creation and emailing of reports.
Resource materials include instructions for use of the BioPaddles®, detailed fact sheets for each agar type and microbe genera (along with selected species) – including microhabitat preferences, procedures for common microbiological techniques, and examples of microbe growth on BioPaddles® from a variety of microhabitat sources.
AppAdvice does not own this application and only provides images and links contained in the iTunes Search API, to help our users find the best apps to download. If you are the developer of this app and would like your information removed, please send a request to takedown@appadvice.com and your information will be removed.